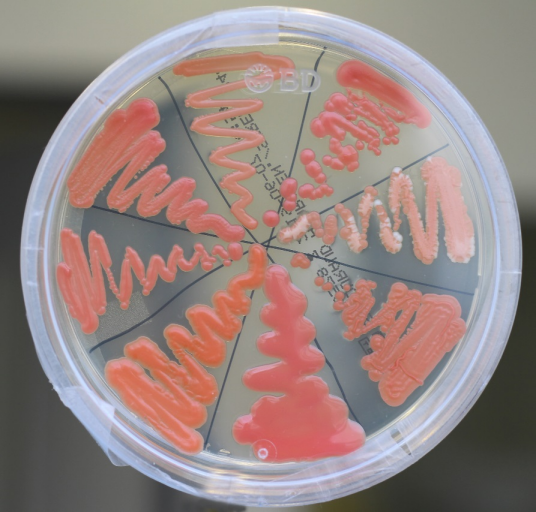

Rhodotorula spp. in the gut – foe or friend?
Herbert Hof 11 MVZ Labor Limbach und Kollegen
Abstract
Rhodotorula spp. belong to the basidiomyceteous fungi. They are widespread in the environment. Transmission to humans occur mainly through air and food. Intestinal colonization is rather common, but an overgrowth is normally suppressed, since their optimal growth temperature is exceeded in the body. A massive presence in the gut indicates a disturbance of the balance of the microbial flora due to different causes. One particular reason will be the treatment with azoles because this will create an advantage for these azole resistant fungi. First of all, the finding of increased numbers of Rhodotorula in stool specimen is not alarming. In contrast, the colonized human will profit from such a situation since these fungi produce a lot of useful nutrients such as proteins, lipids, folate, and carotinoids. Furthermore, a probiotic effect due to regulation of multiplication of pathogenic bacteria and by neutralizing or destroying their toxins can be anticipated. On the other hand, their massive presence may increase the risk of fungemia and ensuing organ infections especially when the host defense system is hampered. Indeed, Rhodotorula spp. range among the emerging fungal pathogens in the compromised host. However, it can be doubted whether all these opportunistic infections reported originate primarily from the gut.
Schlüsselwörter
Mycobiom, Darm, Rhodotorula, basidiomyetische Sproßpilze, ölhaltige Sproßpilze, Karotinoide
Introduction
The mycobiome in the human intestinal tract consists of a plethora of various genera and species [1], among them are moulds as well as yeasts. The role of the various moulds remains largely unknown yet whereby the yeast population has gained much more interest until now. Especially the pathogenic role of intestinal Candida spp. and Saccharomyces spp. has been discussed extensively [2], [3] whereas the relevance of Rhodotorula spp. is hardly acknowleged although they are often found in stool specimen of humans [1], [4]. Intestinal colonization in healthy children is found in up to 5% and in young adults even in 12% [5]. Then again, these yeasts have been declared as emerging pathogens inducing fungemia [6], [7], [8], [9] often associated with central catheters [8] and even solid organ infections such as endogenous endophthalmitis [10].
Biology
In contrast to the ascomycetous yeasts such as Saccharomyces spp. and Candida spp., Rhodotorula spp. belong to the vast phylum of basidiomycetes namely to the family of Sporidiobolales. Typically, Rhodotorula spp. produce carotinoids which cause pink to red colonies on agar (Figure 1 [Fig. 1]). (One should be aware that the red colonies of the bacterium Serratia marcescens are due to the pigment prodigiosin). Furthermore, they belong to the oleaginous yeasts characterized by the fact that up to 50% of their dry weight consist of lipids [11]. The optimal temperature for growth is between 18 and 22°C. In vitro, the growth is reduced at temperatures >33°C [12], [13]. The fungus produces unicellular blastoconidia but does not generate pseudohyphae or even hyphae.
Figure 1: Appearancies of various colonies of Rhodotorula spp. on Sabouraud agar. 5 days after incubation at 30°C. Note the variable colour shades and roughnesses.
Actually, there are 8 species of the genus Rhodotorula known and several of them are found in humans for example R. glutinis, R. minuta, and R. mucilaginosa. Since these fungi are tolerant to dryness, they are able to survive in the environment [12]. Hence, this genus can be found almost everywhere in the surroundings, namely in the air – Rhodotorula is one of the most common fungi transmitted by air – in soil and water, namely ocean seas as well as lakes, in many kinds of fruits and berries (for example strawberries), milk, toothbrushes and shower curtains. Since these yeasts are endowed with a definite affinity for plastic materials [8], they can be often detected in medical devices, for example on plastic catheters [14], [15] and dental equipments [16] where they will grow in form of biofilms [17]. Furthermore, they colonize often hands of medical staff [8], [18].
Obviously, they are taken up regularly by mammals as well as humans via food, which may lead to intermittent or even permanent gut colonization even in healthy subjects [1], [5], [19] not least because they are relatively resistant to bile [12] in comparison to Candida albicans being susceptible to bile acids to some extent [20].
Antimycotic susceptibilities
Amphotericin B is the most active agent [9]. Furthermore, synergisms between amphotericin B and various non-antifungals have been reported [21]. Flucytosine is also reliably active (Table 1 [Tab. 1]). In general, however, isolates of Rhodotorula spp. are resistant to fluconazole and only poorly susceptible to posaconazole and voriconazole [17], [18], [22], [23], [24]. Consequently, these yeasts have a chance to be selected especially in a clinical setting in patients under a longlasting therapeutic regimen with azoles, i.e. fluconazole or posaconazole [25]. Since Rhodotorula spp. belong to the basidiomycetes, which quite typically do not contain1-3-β-glucan in their cell wall, they are intrinsically resistant to echinocandins. Hence, colonizations and even breakthrough infections are also reported in patients treated with echinocandins [15].
Table 1: Antimicrobial susceptibilities of Rhodotorula spp. (according to [22])
Detrimental effects (foe)
Metabolic disturbances
At least in vitro, Rhodotorula spp. like many other oleaginous fungi are enabled to metabolize avidly short-chain fatty acids such as acetic, propionic and butyric acid [26]. Therefore, it could be expected that a massive presence of Rhodotorula spp. in the gut could lead to a shortage of those bacterial products. A loss of their beneficial functions, i.e. their anti-inflammatory, anti-oxidative, anti-cancer and antibacterial effects, would be definitely a disadvantage for the host. Furthermore, these short-chain fatty acids are essential for the function of the gut epithelium, liver and brain [27]. However, substantiated data on the influence of Rhodotorula spp. on the fatty acid metabolism and composition in the human gut are still lacking.
Invasion
Especially in the German literature the phenomenon of “persorption”, which means a paracellular translocation of particles and microorganisms including yeasts across the gut wall, has been discussed over centuries [28]. However, the gut epithelium with tight junctions interconnecting the epithelial cells and restricting the passage of particles and microorganisms through the paracellular space represents a solid anatomical barrier inhibiting the unlimited passage of microorganisms.
There are three main pathophysiological groups of persons where intestinal barrier failure can be definitely observed [29], [30]:
- in patients undergoing abdominal surgery,
- in critically ill patients for example cancer patients suffering from mucositis after cytostatic therapy,
- in patients with chronic pathologic conditions such as HIV infection, liver cirrhosis or inflammatory bowel disease.
Hence, translocation of pathogens from the gut through a dysfunctional mucosal barrier to the mesenteric lymph nodes, the portal vein, and the systemic circulation, eventually leading to sepsis and infectious metastases in various organs, may happen. And even in healthy subjects, this may occur occasionally without any deleterious consequences. A baseline rate of 5–10% of spontaneous translocation of intestinal microorganisms has been estimated to occur in humans [31]. Rhodotorula spp. in particular have been suspected to disrupt this barrier to a certain extent [32] presumably facilitating passage. Fungemia [6], [7], [8], [9] and organ infections [10] due to Rhodotorula spp. have indeed been described, but it remains obscure, whether in all cases this was directly due to gut colonization [8].
Then again, it has been argued [29], [31], [33], [34] that the exposure of the local gut immune system to microbial antigens will have favorable consequences since it may strengthen the defense system of the host in case of a massive invasion and may help to establish tolerance to antigens of commensal microflora.
Allergy
It has been discussed that several yeast antigens, for example mannans, mannoproteins as well as several enzymes such as enolase, in the gut may stimulate the intestinal and furthermore the systemic immune system leading to hypersensitivity against inhaled as well as ingested antigens [35], [36], [37], [38]. Since Rhodotorula spp. also generate those constituents, it could be speculated that they should be able to induce the same hypersensitivities, too.
Beneficial effects (friend)
Fungal products as nutrients
Rhodotorula spp. like many other yeasts may accumulate or secrete proteins and various enzymes [11] such as amylase, cellulase, xylanase etc. contributing to the degradation of the viscosity-generating soluble fibers in food items, considered to be nutritionally advantageous [39]. Fungal proteases have been shown to degrade also bacterial toxins [40]. Furthermore, Rhodotorula is a good producer of folate [39] which is an important micronutrient for all living organisms.
In addition, these oleaginous yeasts are endowed with a particular capacity to form saturated long-chain fatty acids like oleic, linoleic, and in particular palmitic acids, which can be stored in the fungal cells, so that up to 50% of the dry weight of these cells consist of lipids [11]. It remains still obscure actually what this fact finally means for the host. Whereas the role of the bacterial part of the microbiome on the lipid metabolism has been elucidated recently [41], the influence of fungi and especially of oleaginous yeasts such as Rhodotorula has been ignored until now. Hence, it can only be speculated whether the saturated fatty acids represent a high calorie source ensuing a nutritional benefit or whether it may support in some cases obesity.
One characteristic trait of Rhodotorula spp. is the production of different carotinoids giving the fungal colonies their pink appearance. These fungal metabolites can be further converted into vitamin A, which by the way cannot be produced by a human host himself [1]. This vitamin is well known for its protective effects on epithelia [42]. Consequently, it could be expected that it may help to strengthen the intestinal barrier function protecting against bacterial translocations and infections.
By the way, in the future, recombinant strains of Rhodotorula spp. may eventually be used as living cellular carriers delivering various biologically active agents such as insulin into the gut as has been shown in animal experiments [43].
Probiotic effect
Saccharomyces spp. and in particular the so-called S. cerevisiae var. boulardii are used therapeutically in patients with diarrhoea caused by Clostridium difficile, enterohemorrhagic E. coli or Salmonella [44], [45]. At least partially, the positive effects are due to competition with the intestinal flora [40] and especially by binding of pathogenic bacteria or their toxins to the mannan structures in the cell surface of yeasts [46], [47]. In principle, Rhodotorula spp. express similar molecules in their cell wall, and thus, it could be expected that the commensal Rhodotorula spp. also can exert similar beneficial effects. Furthermore, S. boulardii has the potential to interact with the intestinal immune system and to suppress the intestinal inflammation by inhibiting the migration of inflammatory leukocytes from the mesenteric lymph nodes [44]. Then again, not all properties of S. cerevisiae can be replaced by Rhodotorula spp. Whereas oral feeding of mice with living S. cerevisiae stimulated the intestinal epithelium to produce purines which leads to elevated uric acid blood levels above controls, Rhodotorula did not [32].
Evaluation
Although the mycobiome of the gut is numerically definitely smaller than the bacterial community, it may exert a disproportional effect on health or disease [1]. Prolonged treatment with broad-spectrum antibiotics especially with those secreted into the gut such as ciprofloxacin and ceftriaxone can disturb the balance in favor of fungi [43] especially of yeasts and among them Rhodotorula spp. belonging to the basidiomycetes. The additional therapy with metronidazole, eliminating the anaerobic bacteria will further enhance the fungal overgrowth [48]. An antagonism between bacteria such E. coli and Rhodotorula in particular has been observed already long time ago [12]. Whereas in older publications [12] it has been reported, that Rhodotorula are cultured in stool specimen rather rarely, today yeasts of this genus are the most common yeasts in stool specimen besides Saccharomyces spp. and Candida spp. [5], [19], [32]; indeed the numbers detected are quite considerable in some cases. It can be argued that the frequent use of fluconazole and echinocandins, respectively, for therapy and prophylaxis of yeast infections may have contributed to this fact, since Rhodotorula spp., which are intrinsically resistant to these antimycotic agents (Table 1 [Tab. 1]), will profit from such a selective pressure. The overgrowth of Rhodotorula spp. in the gut occurs in spite of non-favorable conditions. Because the optimal growth temperature for Rhodotorula spp. is between 28 and 22°C [12], [13] and the multiplication rate is limited at temperatures >33°C, in normal, healthy individuals the number of Rhodotorula spp. in the gut will be restricted. The fact that increased numbers of Rhodotorula spp. in stool specimen of sick patients after various medical interventions are found rather often [1], [4], [8] indicates, however, a definite alteration of the milieu and a disturbed balance in the microbial population in the gut of those individuals. Obviously, these fungi can survive and multiply in the extreme, unfavorable conditions in the gut. A relative resistance to bile acids [12] may facilitate the colonization.
The question here is, which role plays the fungal flora in the gut. It is well accepted that commensal, low-virulent fungi in the gut like commensal bacteria are able to induce disease at least in case that the individuals has developed a considerable degree of predisposition [44].
It has been argued that Candida spp. in the gut are relatively often associated with disease, whereas Rhodotorula spp. are not [49]. Although one can assume that Rhodotorula spp. like other microorganisms in the gut may have the chance to cross a dysfunctional intestinal barrier, it remains still uncertain whether this pathway represents really the primary cause of fungemia [8]. Indeed, it can be doubted whether the pathogens found in blood or in solid organs originate from the population found in the stool specimen, since it has to be kept in mind that the ubiquitous and saprophytic Rhodotorula spp. are transmitted rather frequently by water [8], [50] and especially by air [8]. Hence, at least transient colonization not only of the gut but also of other sites such as the skin occurs, which might become subsequently the main source of catheter infections and ensuing fungemia. Most cases of Rhodotorula fungemia are actually associated with contaminated central catheters [6], [7], [8], [9] especially in patients with cytotoxic drugs [3]. Potential pathogenic property of Rhodotorula spp. has long been known and experimental infections of animals are reported [8], [51]. In the last 3 decades it is becoming more and more evident, that R. glutinis, R. minuta and R. mucilaginosa range among the emerging pathogens especially in immunocompromised patients provided with central venous catheters, since Rhodotorula spp. are able to settle on surfaces of implanted materials and to form biofilms there [8]. In comparison to the high prevalence of Candida spp. in blood cultures the frequency of Rhodotorula spp., however, remains still relatively low [8].
Yeasts in the gut are not only innocent commensal bystanders [44]. They may induce not only infections, but they may trigger metabolic disturbances [4], [19] and engender allergy [35], [36], [37], [38]. It can be assumed that Rhodotorula spp. exert at least partially similar effects [26].
Then again, a host will profit to some extent from Rhodotorula spp. in his gut, since these yeast produce nutrients such as lipids, carotinoids, folate and proteins [1], [11], [39]. In addition, fungal enzymes may help to digest vegetable food [39]. A probiotic effect may be exerted by binding [46], [47] or destroying bacterial toxins for example those from C. difficile [40]. However, the probiotic effect of Rhodotorula may be lower than that of Saccharomyces and other ascomycetic yeasts, since Rhodotorula spp. like all basidiomycetes do not possess 1-3-β-glucan in their cell wall, so that these fungi will not be able to trigger the dectin 1-receptor on the surface of macrophages. Consequently, it can be anticipated that a stimulation of the local immune system will not happen.
Now, overall Rhodotorula spp. obviously will have certain beneficial impacts on the health of colonized humans; hence an eradication is not indicated in every case. But on the other hand these opportunistic fungi are principally able to induce serious infections at least in the compromised patient. Thus, a definitive assessment whether Rhodotorula spp. are foes or friends is actually not yet possible, since the knowledge about this neglected and underestimated yeast is still incomplete. Hence, some of the above remarks will possibly not be maintained over time.
Conclusion
Rhodotorula spp. belong to the basidiomycetic fungi. They are widespread in the environment. Transmission to humans occur mainly through air and food. Intestinal colonization is rather common, but an overgrowth is normally suppressed, since their optimal growth temperature is exceeded in the body. A massive presence in the gut indicates a disturbance of the balance of the microbial flora due to different causes. One particular reason will be the treatment with azoles, because this will create an advantage for these azole resistant fungi. First of all, the finding of increased numbers of Rhodotorula in stool specimen is not alarming. In contrast, the colonized human will profit from such a situation, since these fungi produce a lot of useful nutrients such as proteins, lipids, folate and carotinoids. Furthermore, a probiotic effect due to regulation of multiplication of pathogenic bacteria ad by neutralizing or destroying their toxins can be anticipated. On the other hand, their massive presence may increase the risk of fungemia and ensuing organ infections especially when the host defense system is hampered. Indeed, Rhodotorula spp. range among the emerging fungal pathogens in the compromised host. It can be doubted, however, whether all these opportunistic infections reported originate primarily from the gut.
Notes
Competing interests
The author declares that he has no competing interests.
References
[1] Hof H. Pilze im Darm – das Mykobiom des Darms [Fungi in the gut – the gut mycobiome]. Z Gastroenterol. 2017 Aug;55(8):772-8. DOI: 10.1055/s-0043-112657[2] Gouba N, Drancourt M. Digestive tract mycobiota: a source of infection. Med Mal Infect. 2015 Jan-Feb;45(1-2):9-16. DOI: 10.1016/j.medmal.2015.01.007
[3] Tligui H, Oudaina W, El Ftouh S, Madda F, Hesseissen L. Une ulcération cutanée due à Rhodotorula mucilaginosa chez un enfant immunodéprimé [A skin ulcer infection due to Rhodotorula mucilaginosa in an immunocompromised child]. J Mycol Med. 2018 Mar;28(1):215-7. DOI: 10.1016/j.mycmed.2018.01.006
[4] Borges FM, de Paula TO, Sarmiento MRA, de Oliveira MG, Pereira MLM, Toledo IV, Nascimento TC, Ferreira-Machado AB, Silva VL, Diniz CG. Fungal Diversity of Human Gut Microbiota Among Eutrophic, Overweight, and Obese Individuals Based on Aerobic Culture-Dependent Approach. Curr Microbiol. 2018 Jun;75(6):726-35. DOI: 10.1007/s00284-018-1438-8
[5] Strati F, Di Paola M, Stefanini I, Albanese D, Rizzetto L, Lionetti P, Calabrò A, Jousson O, Donati C, Cavalieri D, De Filippo C. Age and Gender Affect the Composition of Fungal Population of the Human Gastrointestinal Tract. Front Microbiol. 2016;7:1227. DOI: 10.3389/fmicb.2016.01227
[6] De Almeida GM, Costa SF, Melhem M, Motta AL, Szeszs MW, Miyashita F, Pierrotti LC, Rossi F, Burattini MN. Rhodotorula spp. isolated from blood cultures: clinical and microbiological aspects. Med Mycol. 2008 Sep;46(6):547-56. DOI: 10.1080/13693780801972490
[7] Tuon FF, Costa SF. Rhodotorula infection. A systematic review of 128 cases from literature. Rev Iberoam Micol. 2008 Sep;25(3):135-40.
[8] Wirth F, Goldani LZ. Epidemiology of Rhodotorula: an emerging pathogen. Interdiscip Perspect Infect Dis. 2012;2012:465717. DOI: 10.1155/2012/465717
[9] Ioannou P, Vamvoukaki R, Samonis G. Rhodotorula species infections in humans: A systematic review. Mycoses. 2019 Feb;62(2):90-100. DOI: 10.1111/myc.12856
[10] Luong PM, Kalpakian B, Jaeger LJ, Lahey T, Chapman CB, Zegans ME. Endogenous Endophthalmitis: A Novel Harbinger of the Injection Drug Epidemic in the United States. Case Rep Infect Dis. 2017;2017:9686353. DOI: 10.1155/2017/9686353
[11] Xue SJ, Chi Z, Zhang Y, Li YF, Liu GL, Jiang H, Hu Z, Chi ZM. Fatty acids from oleaginous yeasts and yeast-like fungi and their potential applications. Crit Rev Biotechnol. 2018 Nov;38(7):1049-60. DOI: 10.1080/07388551.2018.1428167
[12] Staib F. Rhodotorula, ihr Vorkommen im menschlichen Körper. Zbl Bakt I Abt Orig. 1956;167:86-93.
[13] Staib F. Rhodotorula in der Galle des Menschen. Zbl Bakt I Abt Orig. 1958;172:142-6.
[14] Kitazawa T, Ishigaki S, Seo K, Yoshino Y, Ota Y. Catheter-related bloodstream infection due to Rhodotorula mucilaginosa with normal serum (1→3)-β-D-glucan level. J Mycol Med. 2018 Jun;28(2):393-5. DOI: 10.1016/j.mycmed.2018.04.001
[15] Wang CH, Hsueh PR, Chen FL, Lee WS. Breakthrough fungemia caused by Rhodotorula mucilaginosa during anidulafungin therapy. J Microbiol Immunol Infect. 2019 Aug;52(4):674-75. DOI: 10.1016/j.jmii.2018.01.001
[16] Damasceno JL, Dos Santos RA, Barbosa AH, Casemiro LA, Pires RH, Martins CHG. Risk of Fungal Infection to Dental Patients. ScientificWorldJournal. 2017;2017:2982478. DOI: 10.1155/2017/2982478
[17] Nunes JM, Bizerra FC, Ferreira RC, Colombo AL. Molecular identification, antifungal susceptibility profile, and biofilm formation of clinical and environmental Rhodotorula species isolates. Antimicrob Agents Chemother. 2013 Jan;57(1):382-9. DOI: 10.1128/AAC.01647-12
[18] Strausbaugh LJ, Sewell DL, Tjoelker RC, Heitzman T, Webster T, Ward TT, Pfaller MA. Comparison of three methods for recovery of yeasts from hands of health-care workers. J Clin Microbiol. 1996 Feb;34(2):471-3.
[19] Kowalewska B, Zorena K, Szmigiero-Kawko M, Wąż P, Myśliwiec M. Higher diversity in fungal species discriminates children with type 1 diabetes mellitus from healthy control. Patient Prefer Adherence. 2016;10:591-9. DOI: 10.2147/PPA.S97852
[20] Guinan J, Villa P, Thangamani S. Secondary bile acids inhibit Candida albicans growth and morphogenesis. Pathog Dis. 2018 04;76(3). DOI: 10.1093/femspd/fty038
[21] Spader TB, Ramírez-Castrillón M, Valente P, Alves SH, Severo LC. In Vitro Interactions of Amphotericin B Combined with Non-antifungal Agents Against Rhodotorula mucilaginosa Strains. Mycopathologia. 2019 Feb;184(1):35-43. DOI: 10.1007/s11046-019-0317-6
[22] Zaas AK, Boyce M, Schell W, Lodge BA, Miller JL, Perfect JR. Risk of fungemia due to Rhodotorula and antifungal susceptibility testing of Rhodotorula isolates. J Clin Microbiol. 2003 Nov;41(11):5233-5. DOI: 10.1128/jcm.41.11.5233-5235.2003
[23] Diekema DJ, Petroelje B, Messer SA, Hollis RJ, Pfaller MA. Activities of available and investigational antifungal agents against rhodotorula species. J Clin Microbiol. 2005 Jan;43(1):476-8. DOI: 10.1128/JCM.43.1.476-478.2005
[24] Falces-Romero I, Cendejas-Bueno E, Romero-Gómez MP, García-Rodríguez J. Isolation of Rhodotorula mucilaginosa from blood cultures in a tertiary care hospital. Mycoses. 2018 Jan;61(1):35-9. DOI: 10.1111/myc.12703
[25] Potenza L, Chitasombat MN, Klimko N, Bettelli F, Dragonetti G, Del Principe MI, Nucci M, Busca A, Fracchiolla N, Sciumè M, Spolzino A, Delia M, Mancini V, Nadali GP, Dargenio M, Shadrivova O, Bacchelli F, Aversa F, Sanguinetti M, Luppi M, Kontoyiannis DP, Pagano L. Rhodotorula infection in haematological patient: Risk factors and outcome. Mycoses. 2019 Mar;62(3):223-9. DOI: 10.1111/myc.12875
[26] Kolouchová I, Schreiberová O, Sigler K, Masák J, Řezanka T. Biotransformation of volatile fatty acids by oleaginous and non-oleaginous yeast species. FEMS Yeast Res. 2015 Nov;15(7). pii: fov076. DOI: 10.1093/femsyr/fov076
[27] Marzocco S, Fazeli G, Di Micco L, Autore G, Adesso S, Dal Piaz F, Heidland A, Di Iorio B. Supplementation of Short-Chain Fatty Acid, Sodium Propionate, in Patients on Maintenance Hemodialysis: Beneficial Effects on Inflammatory Parameters and Gut-Derived Uremic Toxins, A Pilot Study (PLAN Study). J Clin Med. 2018 09;7(10). pii: E315. DOI: 10.3390/jcm7100315
[28] Volkheimer G. Das Phänomen der Persorption--Historie und Fakten [The phenomenon of persorption--history and facts]. Z Arztl Fortbild (Jena). 1993 Mar;87(3):217-21.
[29] Assimakopoulos SF, Triantos C, Thomopoulos K, Fligou F, Maroulis I, Marangos M, Gogos CA. Gut-origin sepsis in the critically ill patient: pathophysiology and treatment. Infection. 2018 Dec;46(6):751-60. DOI: 10.1007/s15010-018-1178-5
[30] Assimakopoulos SF, Triantos C, Maroulis I, Gogos C. The Role of the Gut Barrier Function in Health and Disease. Gastroenterology Res. 2018 Aug;11(4):261-3. DOI: 10.14740/gr1053w
[31] Sedman PC, Macfie J, Sagar P, Mitchell CJ, May J, Mancey-Jones B, Johnstone D. The prevalence of gut translocation in humans. Gastroenterology. 1994 Sep;107(3):643-9. DOI: 10.1016/0016-5085(94)90110-4
[32] Chiaro TR, Soto R, Zac Stephens W, Kubinak JL, Petersen C, Gogokhia L, Bell R, Delgado JC, Cox J, Voth W, Brown J, Stillman DJ, O'Connell RM, Tebo AE, Round JL. A member of the gut mycobiota modulates host purine metabolism exacerbating colitis in mice. Sci Transl Med. 2017 03;9(380). pii: eaaf9044. DOI: 10.1126/scitranslmed.aaf9044
[33] Vaishnavi C. Translocation of gut flora and its role in sepsis. Indian J Med Microbiol. 2013 Oct-Dec;31(4):334-42. DOI: 10.4103/0255-0857.118870
[34] Wiest R, Lawson M, Geuking M. Pathological bacterial translocation in liver cirrhosis. J Hepatol. 2014 Jan;60(1):197-209. DOI: 10.1016/j.jhep.2013.07.044
[35] Yamaguchi N, Sugita R, Miki A, Takemura N, Kawabata J, Watanabe J, Sonoyama K. Gastrointestinal Candida colonisation promotes sensitisation against food antigens by affecting the mucosal barrier in mice. Gut. 2006 Jul;55(7):954-60. DOI: 10.1136/gut.2005.084954
[36] Schulze J, Sonnenborn U. Yeasts in the gut: from commensals to infectious agents. Dtsch Arztebl Int. 2009 Dec;106(51-52):837-42. DOI: 10.3238/arztebl.2009.0837
[37] Hoffmann C, Dollive S, Grunberg S, Chen J, Li H, Wu GD, Lewis JD, Bushman FD. Archaea and fungi of the human gut microbiome: correlations with diet and bacterial residents. PLoS ONE. 2013;8(6):e66019. DOI: 10.1371/journal.pone.0066019
[38] Wheeler ML, Limon JJ, Bar AS, Leal CA, Gargus M, Tang J, Brown J, Funari VA, Wang HL, Crother TR, Arditi M, Underhill DM, Iliev ID. Immunological Consequences of Intestinal Fungal Dysbiosis. Cell Host Microbe. 2016 Jun;19(6):865-73. DOI: 10.1016/j.chom.2016.05.003
[39] Korhola M, Hakonen R, Juuti K, Edelmann M, Kariluoto S, Nyström L, Sontag-Strohm T, Piironen V. Production of folate in oat bran fermentation by yeasts isolated from barley and diverse foods. J Appl Microbiol. 2014 Sep;117(3):679-89. DOI: 10.1111/jam.12564
[40] Limon JJ, Skalski JH, Underhill DM. Commensal Fungi in Health and Disease. Cell Host Microbe. 2017 Aug;22(2):156-65. DOI: 10.1016/j.chom.2017.07.002
[41] Just S, Mondot S, Ecker J, Wegner K, Rath E, Gau L, Streidl T, Hery-Arnaud G, Schmidt S, Lesker TR, Bieth V, Dunkel A, Strowig T, Hofmann T, Haller D, Liebisch G, Gérard P, Rohn S, Lepage P, Clavel T. The gut microbiota drives the impact of bile acids and fat source in diet on mouse metabolism. Microbiome. 2018 08;6(1):134. DOI: 10.1186/s40168-018-0510-8
[42] Hof H. Vitamin A, das „anti-infektive“ Vitamin [Vitamin A, the “anti-infective“ vitamin? (author’s transl)]. MMW Munch Med Wochenschr. 1976 Nov;118(46):1485-8.
[43] Fei Z, Li S, Wang J, Wang Y, Jiang Z, Huang W, Sun H. Rhodotorula glutinis as a living cell liposome to deliver polypeptide drugs in vivo. Drug Deliv. 2019 Dec;26(1):51-62. DOI: 10.1080/10717544.2018.1551439
[44] Iliev ID, Underhill DM. Striking a balance: fungal commensalism versus pathogenesis. Curr Opin Microbiol. 2013 Jun;16(3):366-73. DOI: 10.1016/j.mib.2013.05.004
[45] Moré MI, Swidsinski A. Saccharomyces boulardii CNCM I-745 supports regeneration of the intestinal microbiota after diarrheic dysbiosis - a review. Clin Exp Gastroenterol. 2015;8:237-55. DOI: 10.2147/CEG.S85574
[46] Gedek BR. Adherence of Escherichia coli serogroup O 157 and the Salmonella typhimurium mutant DT 104 to the surface of Saccharomyces boulardii. Mycoses. 1999;42(4):261-4.
[47] Tiago FC, Martins FS, Souza EL, Pimenta PF, Araujo HR, Castro IM, Brandão RL, Nicoli JR. Adhesion to the yeast cell surface as a mechanism for trapping pathogenic bacteria by Saccharomyces probiotics. J Med Microbiol. 2012 Sep;61(Pt 9):1194-207. DOI: 10.1099/jmm.0.042283-0
[48] Trenschel R, Peceny R, Runde V, Elmaagacli A, Dermoumi H, Heintschel von Heinegg E, Müller KD, Schaefer UW, Beelen DW. Fungal colonization and invasive fungal infections following allogeneic BMT using metronidazole, ciprofloxacin and fluconazole or ciprofloxacin and fluconazole as intestinal decontamination. Bone Marrow Transplant. 2000 Nov;26(9):993-7. DOI: 10.1038/sj.bmt.1702655
[49] Suhr MJ, Hallen-Adams HE. The human gut mycobiome: pitfalls and potentials – a mycologist’s perspective. Mycologia. 2015 Nov-Dec;107(6):1057-73. DOI: 10.3852/15-147
[50] Jankowski M, Charemska A, Czajkowski R. Swimming pools and fungi: An epidemiology survey in Polish indoor swimming facilities. Mycoses. 2017 Nov;60(11):736-8. DOI: 10.1111/myc.12654
[51] Thomson P, López-Fernández L, Guarro J, Capilla J. Virulence and antifungal therapy of murine disseminated infection by Rhodotorula mucilaginosa. Diagn Microbiol Infect Dis. 2017 Sep;89(1):47-51. DOI: 10.1016/j.diagmicrobio.2017.06.005



